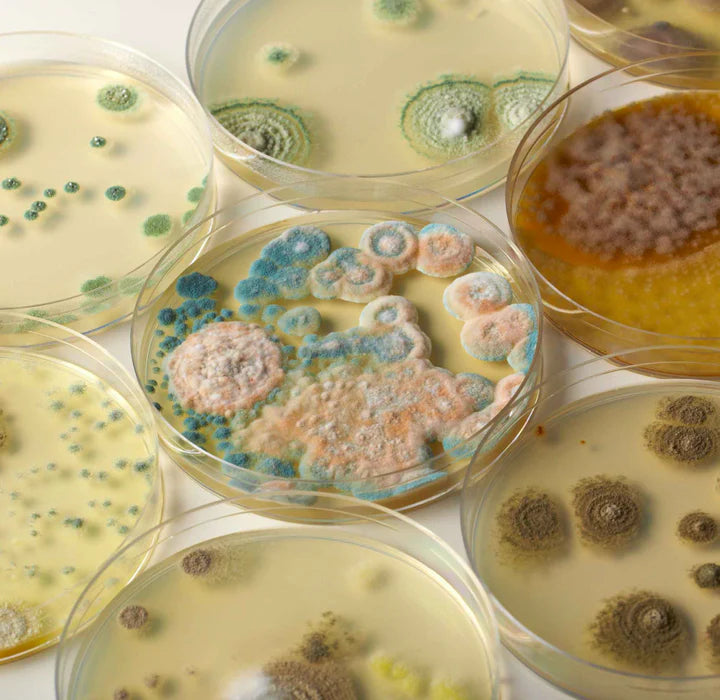

Revolting Science Kit
The Bacteria Farm is a great first biology kit for any budding scientist. Cultivate & observe bacteria from different samples with a variety of experiments.
Revolting Science is a gross science kit that allows kids to explore the fascinating world of bacteria with hands-on experiments. Featuring easy-to-follow instructions and high-quality materials, it is an ideal tool to introduce kids to microbial science in a fun and interactive way.
Product Dimensions (cm): 25 X 19 X 6
Ages 8+